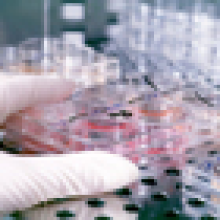

Cauzele infertilității și progresele...
Unul din patru cupluri din țările în curs de dezvoltare s-a dovedit a fi afectat de...

Povestea plină de încăpățânare a primei femei arheolog din Transilvania, Zsófia Torma

Regina Elisabeta, prima regină a României. Femeia care a cucerit inimile românilor cu bunătatea și iubirea ei nemărginită pentru poporul al cărui sânge nu-i curgea prin vene

Prima femeie care a devenit miliardară EXCLUSIV din muzică și care a schimbat regulile în industria muzicală. Povestea succesului lui Taylor Swift

Pictorița care a pictat spiritul unei epoci, Cecilia Cuțescu-Storck, prima femeie profesor la o universitate de artă de stat din Europa

Importanța alegerii unui stilou de calitate pentru elevii la început de drum

Moartea e neînduplecată. N-are ceas, nici inimă, nu te-așteaptă să îți mai îmbrățișezi o dată tatăl sau să îi ceri iertare mamei

CHRIS HEMSWORTH: O CĂLĂTORIE DE NEUITAT – UN DOCUMENTAR EMOȚIONANT DESPRE PUTEREA AMINTIRILOR ȘI CONEXIUNE

De ce sunt importante enciclopediile pentru copii în era digitală?

Secretele unui flirt care lasă bărbații fără cuvinte

Intimitățile unei fete cuminți

Cum îți antrenezi inima să nu mai cadă în aceeași capcană

Cum să-l faci să se îndrăgostească de tine: 7 Strategii psihologice care funcționează

Uneori, oamenii răniți rănesc alți oameni... Nu pentru că sunt rai, ci pentru că nu știu cum SĂ NU-și dea rana mai departe

Uneori prieteniile încheiate dor mai tare decât despărțirile romantice

Ce NU trebuie să faci când ești trist sau CUM să treci prin tristețe cu blândețe

Iubești ideea de iubire sau pe omul din fața ta? Semne clare că nu ești chiar atât de îndrăgostit/ă pe cât credeai

Baby Boom Show începe joi, 4 septembrie - cel mai mare târg din România pentru copii şi viitori părinţi!

Antonio Pican, Bibi, Iuliana Beregoi și mulți alții cântă la FestiKids 2025, singurul festival cu acces GRATUIT

Fragment în exclusivitate din cartea de dezvoltare personală pentru copii „Cele 7 obişnuinţe ale copiilor fericiţi”

Începe FestiKids 2025, singurul festival pentru copii cu INTRARE LIBERĂ. ROMEXPO - 30 MAI - 1 IUNIE

Rugăciune către Sfânta Muceniță Filofteia pentru vindecarea de boală și durere

Oglinzile timpului: sensul numerelor 12:21 și 21:12 și mesajele lor pentru tine

Test de spiritualitate: Ce număr magic îți va ghida destinul în 2026?

Decembrie 2025 -Luna care închide anul activând energia Trinității și puterea lui 3! Binecuvântări divine, deschideri de destine

De ce apar mai des infecțiile urinare la femei în sezonul rece și cum le putem preveni

Galactocel la sân - cauze, tratament

10 semne că picioarele tale au nevoie de mai multă atenție

Regenerare cu celule stem mezenchimale, o nouă speranță pentru pacienții cu boli de ficat

Usturoiul fermentat în miere – elixirul antic natural care vindecă din interior

Hrana care păstrează tinerețea: 9 alimente esențiale pentru frumusețe, vitalitate și echilibru

Farmacia din pădure: Ciuperca minune care contribuie la combaterea cancerului

Care sunt ceaiurile potrivite pentru a fi consumate toamna

Beneficiile consumului de Ashwagandha, rădăcina energiei și planta sacră a echilibrului cu o istorie de peste 3.000 de ani

Yuzu, fructul exotic apreciat de japonezi pentru noroc, aromă și paleta largă de beneficii

Ce este și cum se mănâncă Kaki? Tot ce trebuie să știi despre fructul auriu al toamnei: beneficii și contraindicații

Tot ce trebuie să știi despre RODIE, fructul-minune cu multiple beneficii pentru sănătate în sezonul rece și 3 idei de rețete

Elizabeth Olsen revine pe marile ecrane cu Eternity. Tu pe cine ai alege pentru a-ți petrece... eternitatea?

2NormaL revine la numele real: EDUARD COTOARĂ. Artistul lansează ”Din nou acasă de Crăciun” și anunță un concert extraordinar

Concert Crăciun Imperial – Emoție, eleganță și poveste vieneză în inima Bucureștiului

Stephanie Radu și Alin Stoica, vocile României la Concerto di Natale - sub egida Papei Leone al XIV-lea

Soliști ai Operei Naționale din București, recital la Scala din Milano pe 3 decembrie, în Il Ridotto dei Palchi Arturo Toscanini

Opera Națională București deschide oficial Anul Cultural România - Italia 2026 printr-un Concert de Gală susținut la Roma

Viața secretă a emoțiilor de Ilaria Gaspari – sau ce ne învață fiecare emoție pe care o trăim

O săptămână de teatru, colinde și concert vienez în marile orașe ale țării

Optimizare SEO pentru lead-uri și vânzări pe pilot automat

De la pasiune la profit: 4 pași cheie pentru a-ți transforma visul într-o afacere de succes

Biroul tău, cartea de vizită a afacerii: 4 detalii care construiesc o imagine de brand puternică

Singura româncă din topul celor mai bogate femei din SUA își spune povestea inspirațională în cartea „Conturul unui vis”

Cadouri de Crăciun pentru Companii — cum alegi în 10 minute și livrezi la timp

Cadoul ca instrument de leadership feminin

The Essence of Fashion: descoperă arta construirii unei ținute complete, de la outfit la parfum

Velvet Vibes sau opulența catifelei: 10 piese vestimentare din CATIFEA, materialul trending al toamnei 2025 cu o textură luxoasă

Trucuri simple pentru prăjituri perfecte. Cum să eviți greșelile de coacere

Cannoli la tine acasă în 30 de minute! Desertul sicilian reinventat pentru gusturile românești

Regula simplă care ține durerile de spate sub control. 30 de minute jos, 15 minute în picioare

Trei obiceiuri banale care reduc inflamația din organism

Cum să stilizezi cardiganul din lână: 5 idei de layering

Ce aduce 2026 în moda pantofilor pentru femei

ZARA REDESCHIDE MAGAZINUL DIN SUN PLAZA BUCUREȘTI

Cum alegi geaca perfectă pentru sezonul rece

Velvet nails - unghiile ca de catifea, noul must-have al sezonului rece

Tonice naturale pentru păr: regenerare, echilibru și revenire la ritmul interior

Pedichiura sezonului rece: eleganța care strălucește în detalii

Parfumuri și zodii: Ghid holistic și spiritual pentru aromele care susțin personalitatea și energia fiecărui semn

Decorul ca stare de bine: Idei simple pentru o atmosferă hygge de sărbători

Cum alegi lada frigorifică potrivită pentru iarnă și pentru concedii active

8 lucruri de care ai nevoie pentru renovarea unei bucătării

Cum să-ți transformi grădina într-un spațiu de lux cu o bucătărie de exterior premium

Neptun își reia mersul direct în Pești: Ultimele săptămâni de revelații înainte de o nouă eră cosmică

Horoscop BANI săptămâna 8-14 decembrie 2025

Horoscop săptămânal: Care este ziua ta norocoasă în funcție de zodie în săptămâna 8-14 decembrie 2025?

Ultima Lună Plină a anului este cu noroc pentru 4 zodii, șterge urmele lui Mercur retrograd! Mici minuni practice în viețile lor

Neptun își reia mersul direct în Pești: Ultimele săptămâni de revelații înainte de o nouă eră cosmică

Horoscop BANI săptămâna 8-14 decembrie 2025

Horoscop săptămânal: Care este ziua ta norocoasă în funcție de zodie în săptămâna 8-14 decembrie 2025?

Ultima Lună Plină a anului este cu noroc pentru 4 zodii, șterge urmele lui Mercur retrograd! Mici minuni practice în viețile lor

Neptun își reia mersul direct în Pești: Ultimele săptămâni de revelații înainte de o nouă eră cosmică

Horoscop BANI săptămâna 8-14 decembrie 2025

Horoscop săptămânal: Care este ziua ta norocoasă în funcție de zodie în săptămâna 8-14 decembrie 2025?

Ultima Lună Plină a anului este cu noroc pentru 4 zodii, șterge urmele lui Mercur retrograd! Mici minuni practice în viețile lor
Neptun își reia mersul direct în Pești: Ultimele săptămâni de revelații înainte de o nouă eră cosmică
Ultima Lună Plină a anului este cu noroc pentru 4 zodii, șterge urmele lui Mercur retrograd! Mici minuni practice în viețile lor
Test de spiritualitate: Ce număr magic îți va ghida destinul în 2026?
Venus în Săgetător (30.11 – 23.12.2025): Iubirea devine aventură și aduce poftă de viață. Dragostea se mută în necunoscut
Tarot online: Care va fi atmosfera lunii decembrie 2025 pentru tine?

ABONARE NEWSLETTER
Bucură-te de cele mai frumoase articole Garbo și pe email!

CONTACTAȚI-NE
SAU COMPLETATI FORMULARUL DE MAI JOS.

”Nu mă lăsa să mor” - o poveste de ficțiune despre realitatea dureroasă a singurătății, din 5 decembrie în cinematografe
O joacă a unui tânăr român a dus la reinventarea sistemului de returnare a ambalajelor
McHappy Day 2025®: când faptele bune țin familiile împreună
Prelungim termenul de înscriere ca voluntar pentru copiii abandonați. Ultima zi de înscriere: 10 octombrie